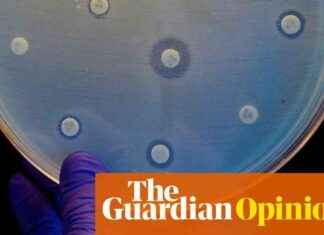
Addressing the Global Antibiotic Crisis: Urgent Data-Driven Action Needed | Sally Davies news-01102024-075920

Uncovering How Legged Fish Use Their Limbs to Locate Food
While delivering a guest lecture on sticklebacks, Stanford University researcher David Kingsley stumbled upon a peculiar fish that piqued his interest. This fish, known as a sea robin, had a body of a fish,...
Mysterious Nova Explosions Triggered by Supermassive Black Hole Jets: Hubble Telescope Discovery
At the heart of nearly every large galaxy in the universe, there is a supermassive black hole that devours anything that comes too close. When these cosmic monsters consume large amounts of energy and...
Discovering Gas Streams in a Distant Galaxy Cluster with NASA’s Chandra X-ray Telescope
NASA's Chandra X-ray telescope has discovered two new streams of superheated gas in a distant galaxy cluster called Zwicky 8338 (Z8338), which is located about 670 million light-years away from Earth. These streams of...
Restoration of Full-Size Space Shuttle Mockup for Downey Display
A full-size model of the space shuttle orbiter, known as "Inspiration," is finally returning to public display after more than 25 years in storage. The City of Downey in California has been working on...
Livestream: Watch the Annular Solar Eclipse Online on Oct. 2
On October 2, 2024, a spectacular annular solar eclipse will grace the sky, creating a mesmerizing "ring of fire" effect. While many of us may not be fortunate enough to witness this phenomenon in...
Challenges in India’s Goal to Eliminate Leprosy by 2027
Tanu Bai's story sheds light on the challenges India faces in achieving its goal of eliminating leprosy by 2027. Despite the government's ambitious Leprosy Mukt Bharat campaign, charity leaders and medical workers remain skeptical...
Debunking the Myth: The Truth About the World’s Oldest People
Dr. Saul Newman, an interdisciplinary researcher at University College London and the University of Oxford, recently received an Ig Nobel prize for his groundbreaking work debunking the myth of the world's oldest people. In...
Britain bids farewell to coal: A podcast on the end of an era
Britain recently bid farewell to coal as the country shut down its last coal-fired power station, Ratcliffe-on-Soar. Madeleine Finlay, along with energy correspondent Jillian Ambrose, visited Nottinghamshire to tour the site before its final...
Addressing the Global Antibiotic Crisis: Urgent Data-Driven Action Needed | Sally Davies
Antibiotic resistance is a growing global crisis that could have devastating consequences if urgent action is not taken. According to recent research, deaths directly attributed to bacterial AMR are on the rise, with over...
Unraveling Netflix’s Revisitation of Ancient Apocalypse: Ice-Age Telepaths Explored
Diary note: it may seem a while off, but the end of the world is still scheduled for 2030, precise date TBC. After once suggesting that nameless devastation could be upon us in 2012,...